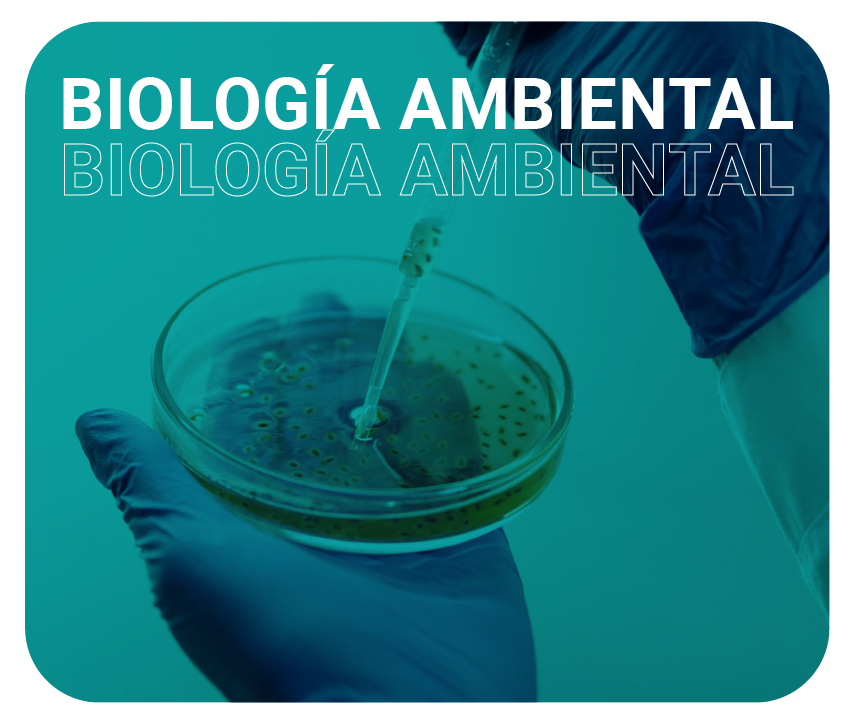

Novedades bibliográficas

El acceso a estos recursos es con el usuario del correo institucional (sin el @utadeo.edu.co) y la clave del correo institucional.
- Facultad de Artes y Diseño
- Facultad de Ciencias Naturales e Ingeniería
- Facultad de Ciencias Sociales
- Facultad de Ciencias Económicas - Administrativas
![]() | ![]() | ![]() |
![]() | ![]() | ![]() |
![]() |
Servicio de Solicitud de tablas de contenido de las revistas, libros relacionados con el tema de su investigación, noticias, cursos, seminarios, etc.
Puede solicitarlo a través de:
Si está interesado en obtener un artículo o capítulo de los índices consultados, puede hacerlo a través del servicio del mismo servicio.